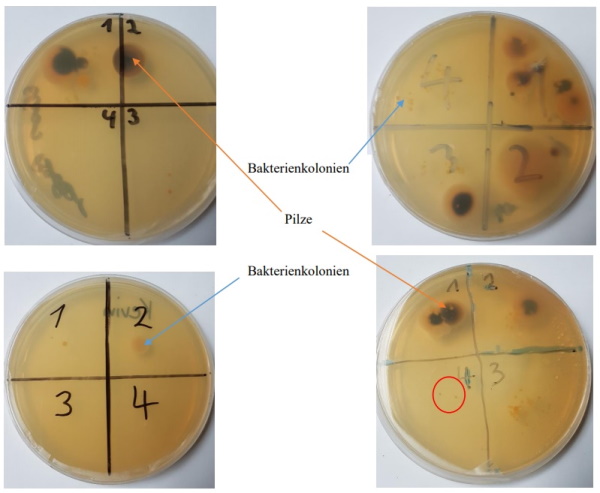

Im Rahmen von bodenbiologischen Untersuchungen im Wahlpflichtfach Natur-Umwelt-Mensch in der 9. Klasse ist nebenbei die Wirkung der Handreinigung untersucht worden. Dabei haben die Schülerinnen und Schüler auf einer sterilen Agarplatte ihre Fingerabdrücke hinterlassen. Die Platten sind anschließend bei 30°C kultiviert worden. Danach ist eine Auswertung durchgeführt worden.
Im Feld 1 ist ein Fingerabdruck ohne vorherige Behandlung, in Feld 2 sind die Hände mit Wasser gewaschen, in Feld 3 mit Seife und Wasser und in Feld 4 sind die Hände desinfiziert. Pilze sind an an ihren Hyphen (Pilzfäden) zu erkennen. Sie sind meist schwarz, weiß oder grün. Bakterien können stäbchenförmige oder kugelige Gestalt annehmen. Sie sind häufig gelb oder weiß. Vier Agarplatten sind exemplarisch unten dargestellt:
Wie sehr gut erkenntlich ist, wirkt die Handreinigung sehr deutlich. Dieses Ergebnis ist durchgehend bei allen Gruppen beobachtet worden. Selbst einfaches Händewaschen wirkt bereits so, dass viele Keime abgewaschen werden. Aber auch bei desinfizierten Fingern (Nr. 4) können noch Bakterien auftreten (s. untere Reihe rechts). Pilzkolonien haben sich dabei auf keiner Agarplatte mehr entwickelt.
Dr. Albin Schüttel, NUM 9